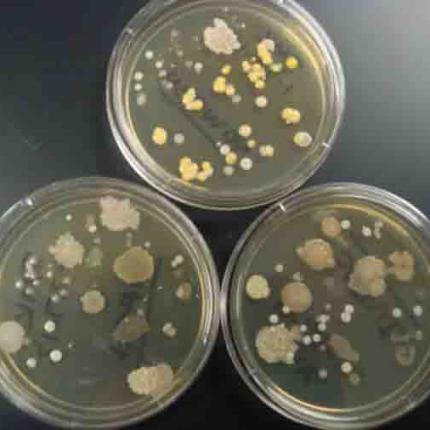
touch-plates-far-sil.jpg

Το DNA των μικροβίων που ζουν στο ανθρώπινο
σώμα μπορεί να χρησιμοποιηθεί για να
ταυτοποιηθεί ένας άνθρωπος, κάτι που...
ΔΑΧΤΥΛΙΚΑ ΑΠΟΤΥΠΩΜΑΤΑ
Body
Ένα πρωτοποριακό εργαλείο έρχεται να βοηθήσει τους ιατροδικαστές και τους αστυνομικούς εντοπίζοντας δαχτυλικά...
Ράδιο Κρήτη © | 2013 -2026
ekriti.gr
Όροι Χρήσης
|
Ταυτότητα
Designed by
Cloudevo, developed by
Pixelthis